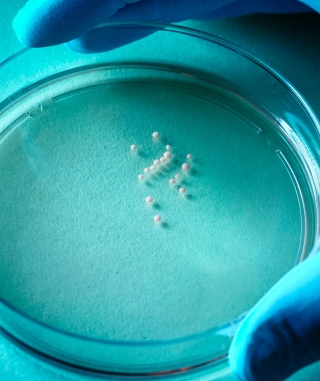

Photo courtesy of Timothy Archibald.
A baby’s time in the womb is one of the most crucial periods in terms of its development. The average length of gestation, which is defined as the amount of time in the womb from conception to birth, is approximately 40 weeks. Unfortunately, for reasons not yet fully understood, there are times that babies are born prematurely, which can lead to problems.
These infants can have underdeveloped portions of the brain, such as the cerebral cortex, which is responsible for advanced brain functions, including cognition, speech, and the processing of sensory and motor information. The brains of premature infants can be so underdeveloped that they are unable to control breathing. This, in combination with underdeveloped lungs, can lower oxygen levels in the blood, which can lead to hypoxic, or low oxygen related, brain injuries.
In a previous study, doctors Anca and Sergiu Pasca and their colleagues at Stanford developed a technique to create a 3D brain that mimics structural and functional aspects of the developing human brain.
Using this same technique, in a new study with the aid of CIRM funding, the team grew a 3D brain that contained cells and genes similar to the human brain midway through the gestational period. They then exposed this 3D brain to low oxygen levels for 48 hours, restored the oxygen level after this time period, and observed any changes.
It was found that progenitor cells in a region known as the subventricular zone, a region that is critical in the growth of the human cortex, are affected. Progenitor cells are “stem cell like” cells that give rise to mature brain cells such as neurons. They also found that the progenitor cells transitioned from “growth” mode to “survival” mode, causing them to turn into neurons sooner than normal, which leads to fewer neurons in the brain and underdevelopment.
In a press release, Dr. Anca Pasca is quoted as saying,
“In the past 20 years, we’ve made a lot of progress in keeping extremely premature babies alive, but 70% to 80% of them have poor neurodevelopmental outcomes.”
The team then tested a small molecule to see if it could potentially reverse this response to low oxygen levels by keeping the progenitor cells in “growth” mode. The results of this are promising and Dr. Sergiu Pasca is quoted as saying,
“It’s exciting because our findings tell us that pharmacologically manipulating this pathway could interfere with hypoxic injury to the brain, and potentially help with preventing damage.”
The complete findings of this study were published in Nature.